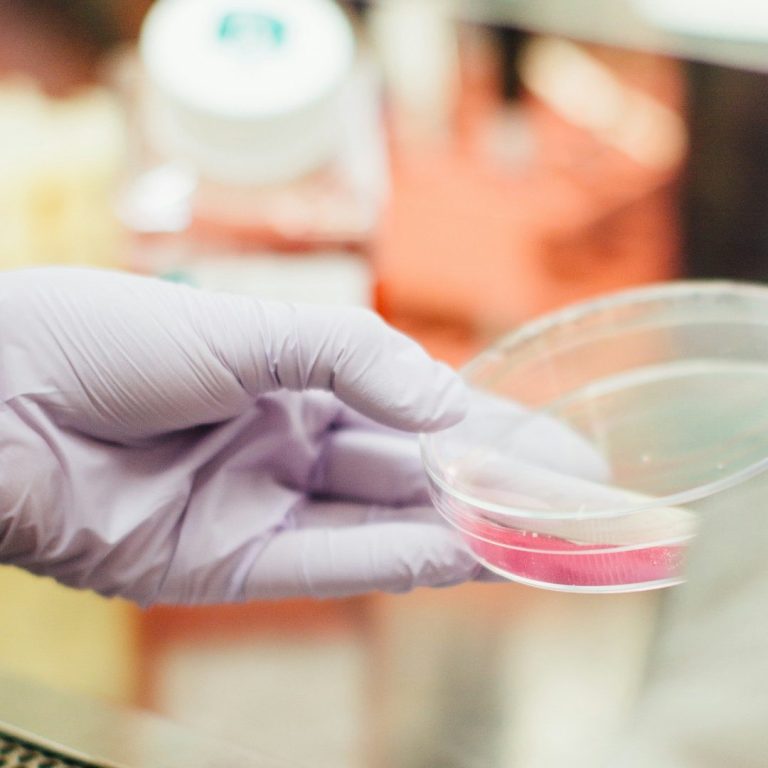

About Us
Who We Are

At Back In Order, LLC, we strive to exceed expectations in medical device distribution. Our mission is to provide top-tier products while ensuring customer satisfaction through personalized support and expert insights.
Get in Touch
Start Your Partnership Today
Join us in delivering exceptional healthcare solutions. Contact us for inquiries, product information, or partnership opportunities.
©Copyright. All rights reserved.
We need your consent to load the translations
We use a third-party service to translate the website content that may collect data about your activity. Please review the details in the privacy policy and accept the service to view the translations.